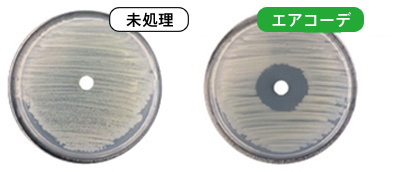

ECSTAR エアコーデ/ エアコーデ ケア2とは?
消臭・除菌※・抗菌コートで車室内空間コーディネート。
車室内の不快物質のすみかであるファブリック(布地)シート等を消臭・除菌※・抗菌コーティングします。
※除菌効果はエアコーデ ケア2のみです。
※ウイルス除去効果はエアコーデ ケア2のみです。
※「ECSTAR エアコーデ」と「ECSTAR エアコーデ ケア2」では施工部分などが異なります。詳しくは下記の比較表をご覧ください。
車室内の不快物質のすみかであるファブリック(布地)シート等を消臭・除菌※・抗菌コーティングします。
※除菌効果はエアコーデ ケア2のみです。
※ウイルス除去効果はエアコーデ ケア2のみです。
※「ECSTAR エアコーデ」と「ECSTAR エアコーデ ケア2」では施工部分などが異なります。詳しくは下記の比較表をご覧ください。
ECSTAR エアコーデ / エアコーデ ケア2のポイント
消臭・防臭効果
汗や食べもの、タバコ、ペット等の多様な臭気源に対して消臭効果を発揮します。
抗菌効果
耐久性に優れる無機系抗菌成分と、即効性に優れる有機系抗菌成分を組み合わせる
『ハイブリッド抗菌効果』。
カビ※や細菌を防ぎ新車の清潔さをキープします。
『ハイブリッド抗菌効果』。
カビ※や細菌を防ぎ新車の清潔さをキープします。
安心・安全
天然由来成分や、化粧品等に用いられる安全性の高い成分を使用しています。
これを実証するために、外部検査機関で人の肌による『パッチテスト』を実施し肌に触れた場合の影響が無いことを確認しております。
これを実証するために、外部検査機関で人の肌による『パッチテスト』を実施し肌に触れた場合の影響が無いことを確認しております。
ウイルス除去※
エンベロープウイルス1種類をつけた基材にエアコーデ ケア2を処理し、所定時間後に99%のウイルス除去効果を確認しました。
※ウイルス除去効果はエアコーデ ケア2のみです。
ECSTAR エアコーデ/エアコーデ ケア2を施工すると繊維表面に消臭・除菌・抗菌被膜を形成
①ニオイ、細菌、ウイルスを
キャッチし分解
キャッチし分解

②細菌・カビを寄せ付けず
繁殖させない。
繁殖させない。

比較表
![]() | ![]() | |
| 施工タイミング | 新車時のみ | 新車時・現在お乗りのお車 |
| 効果 | 消臭・抗菌 | 消臭・除菌・抗菌・ウイルス除去※2 |
| 抗菌効果持続期間※1 | 約1年 | 約3ヵ月 |
| 施工対象 | ファブリックシート、コンビ(革調/ファブリック)シート | 革調、ファブリックシート、コンビ(革調/ファブリック)シート |
| 施工範囲 | シート、天井、ラゲッジ(ファブリック) | シート、ラゲッジ(ファブリック)、フロアマット |
※1 持続期間:製造元による摩擦耐久テストの結果による理論値です。持続期間は目安であり、お車の使用状況によって変わります。
※2 ウイルス除去:エンベロープウイルス1種類をつけた基材にエアコーデ ケア2を処理し、所定時間後に99%のウイルス除去効果を確認しました。(一般財団法人 日本繊維製品品質技術センターによる試験)
※すべてのニオイ・細菌・カビ・ウイルスに効果があるわけではありません。
※空間に浮遊するもの(シートなどが吸着したもの以外)は除去できません。
※エアコーデは本革、革調、ビニールシート車(用品のシートカバー含む)に施工できません。エアコーデ ケア2は本革、ビニールシート車(用品のシートカバー含む)に施工できません。
※用品のシートカバーを装着する場合は、シートカバーを装着後、施工を行ないます。
※ファブリック表皮の撥水加工シートは施工が行なえますが、状況に応じて一部撥水機能が低下することがございます。
※2 ウイルス除去:エンベロープウイルス1種類をつけた基材にエアコーデ ケア2を処理し、所定時間後に99%のウイルス除去効果を確認しました。(一般財団法人 日本繊維製品品質技術センターによる試験)
※すべてのニオイ・細菌・カビ・ウイルスに効果があるわけではありません。
※空間に浮遊するもの(シートなどが吸着したもの以外)は除去できません。
※エアコーデは本革、革調、ビニールシート車(用品のシートカバー含む)に施工できません。エアコーデ ケア2は本革、ビニールシート車(用品のシートカバー含む)に施工できません。
※用品のシートカバーを装着する場合は、シートカバーを装着後、施工を行ないます。
※ファブリック表皮の撥水加工シートは施工が行なえますが、状況に応じて一部撥水機能が低下することがございます。
ECSTAR エアコーデには、メンテナンススプレー(240ml)が1本含まれています。追加購入も可能です。
※新車時のみ施工可能です。
※施工作業料金が別途必要です。詳しくはスタッフまでお尋ねください。
※新車時のみ施工可能です。
※施工作業料金が別途必要です。詳しくはスタッフまでお尋ねください。
消臭・防臭効果
消臭性試験(スズキ調べ)
※各臭気の初期濃度を100%とした場合の消臭吸着性能。
(数値が小さい方が消臭効果が高い)

※各臭気の初期濃度を100%とした場合の消臭吸着性能。
(数値が小さい方が消臭効果が高い)

抗菌効果
※カテキン培地に枯草菌を繁殖させ、未処理のタブレットと、エアコーデを含浸させたタブレットを中心に置く。抗菌作用があれば、タブレットの周りに阻止円ができる。(製造元調べ)
オプション
ECSTAR エアコーデ メンテナンススプレー 2,200円

ECSTAR エアコーデ メンテナンススプレー 2,200円

ニオイが気になる際などに、お手入れ用のメンテナンススプレーをシートへ噴霧することで
消臭・抗菌性能を補います。
消臭・抗菌性能を補います。
※掲載の価格はメーカー希望小売価格(消費税10%込み)で参考価格です。
※価格は販売会社が独自に定めていますので、詳しくは各販売会社へお問い合わせください。
※メーカー希望小売価格は2024年12月現在のもので、予告なく変更する場合があります。
※価格は販売会社が独自に定めていますので、詳しくは各販売会社へお問い合わせください。
※メーカー希望小売価格は2024年12月現在のもので、予告なく変更する場合があります。
※新車への施工には、効果持続期間が約1年の「ECSTAR エアコーデ」もございます。1年点検以降に「ECSTAR エアコーデ ケア2」をご利用ください。
※施工作業料金が別途必要です。詳しくはスタッフまでお尋ねください。
※施工作業料金が別途必要です。詳しくはスタッフまでお尋ねください。
ウイルス除去効果

ウイルス除去試験(一般財団法人 日本繊維製品品質技術センターによる試験)
※未処理のウイルス数を100とした場合の除去率。エンベロープウイルス1種類をつけた基材にエアコーデ ケア2を処理し、所定時間後に99%のウイルス除去効果を確認しました。
※全てのウイルスを除去する訳ではありません。また空間のウイルス除去はできません。
銀イオンxゼオライトの
無機抗菌剤
無機抗菌剤

(-)イオンのゼオライトの三次元骨格内で
(+)イオンの銀イオンを安定化
消臭メカニズム
無数の微細な穴で臭気を吸着

金属イオンが臭気成分を化学的に吸着


金属イオンが臭気成分を化学的に吸着

除菌・抗菌メカニズム

細菌が銀担持ゼオライトと接触することで
①銀イオンが細菌に取り込まれる
②銀イオンが細菌の代謝系酵素と反応し、
働きを阻害
③細菌の増殖が抑制される
消臭・防臭効果
消臭性試験(製造元調べ)
※各臭気の初期濃度を100%とした場合の消臭吸収性能。
(数値が小さい方が消臭効果が高い)

※各臭気の初期濃度を100%とした場合の消臭吸収性能。
(数値が小さい方が消臭効果が高い)

除菌・抗菌効果

※カテキン培地に枯草菌を繁殖させ、未処理のタブレットと、エアコーデ ケア2を含浸させたタブレットを中心に置く。抗菌作用があれば、タブレットの周りに阻止円ができる。(製造元調べ)
※写真は抗菌効果を示したものです。
エアコーデ ケア2とご一緒にいかがですか?
クリーンエアフィルター(高機能タイプ) 3,630円~

車外からのPM2.5や花粉のほか、黄砂・チリ・ホコリ・微粉塵などをフィルターで
キャッチします。
また、キャッチした菌やカビの増殖を抑えて、車内をより快適な環境に保ちます。
キャッチします。
また、キャッチした菌やカビの増殖を抑えて、車内をより快適な環境に保ちます。
※標準装備のエアコンフィルターを取り外して装着します。
※車種により価格・品番が異なります。
※交換の目安は1年または12,000㎞です。
※車種により価格・品番が異なります。
※交換の目安は1年または12,000㎞です。
エアコンクリーナー 2 3,080円

エアコン内部(エバポレーター)で繁殖した細菌やカビ・汚れなどを洗浄と同時に消臭・除菌・ウイルス※1除去。
約12ヶ月※2の間、細菌・カビの繁殖を抑えます。
約12ヶ月※2の間、細菌・カビの繁殖を抑えます。
※1:一般財団法人 日本繊維製品品質技術センターによるエンベロープウイルス1種を用いた試験。
※2:エアコンを1日2時間作動した場合の持続期間目安です。
※すべてのニオイ・細菌・カビ・ウイルスに効果があるわけではありません。
※エアコンフィルターを装着していない車両には施工できません。
※施工作業料金が別途必要です。詳しくはスタッフまでお尋ねください。
※2:エアコンを1日2時間作動した場合の持続期間目安です。
※すべてのニオイ・細菌・カビ・ウイルスに効果があるわけではありません。
※エアコンフィルターを装着していない車両には施工できません。
※施工作業料金が別途必要です。詳しくはスタッフまでお尋ねください。
※掲載の価格はメーカー希望小売価格(消費税10%込み)で参考価格です。
※価格は販売会社が独自に定めていますので、詳しくは各販売会社にお問い合わせください。
※メーカー希望小売価格は2024年12月現在のもので、予告なく変更する場合があります。
※価格は販売会社が独自に定めていますので、詳しくは各販売会社にお問い合わせください。
※メーカー希望小売価格は2024年12月現在のもので、予告なく変更する場合があります。




